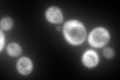
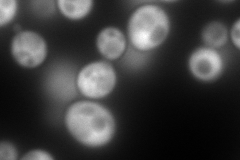
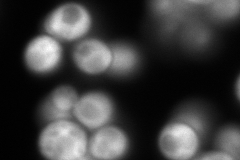
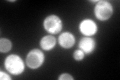

View description
ATPase that is a component of the heat shock protein Hsp90 chaperone complex; binds unfolded proteins; member of the heat shock protein 70 (HSP70) family; localized to the cytoplasm
Localization:
Intensity:
Fold change:
Significance:
-
C’ GFP library in SD
cytosol410.09 -
N' NOP1pr-GFP in SD
cytosol535.927 -
N' TEF2pr-mCherry in SD

cytosol480.443 -
N' NATIVEpr-GFP in SD
cytosol399.483 -
N' TEF2pr-VC and Cyto-VN in SD

cytosol97.141 -
C’ GFP library in SD+DTT

cytosol574.361.4No -
C’ GFP library in SD+H2O2

cytosol599.591.46No -
C’ GFP library in Starvation Media
cytosol533.011.29No -
C’ GFP library on the background of Pup2-DaMP

cytosol -
C’ GFP library on the background of CCT mutant

cytosol533.0151.29973No
